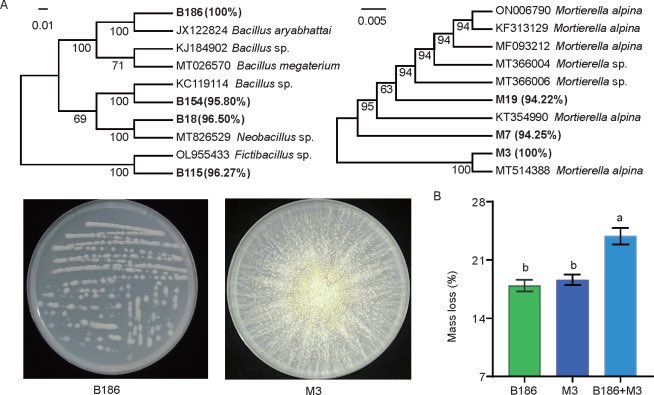
JIA_JIntegrAgri's tweet image. #Wheat cover #crop accelerates the decomposition of #cucumber #root litter by altering the #soil #microbial community
🖇️doi.org/10.1016/j.jia.…
#agroecology

#cucumber search results
Crisp cucumbers! Top tip: grow them on a trellis to save space and get straighter fruit. Ancient Romans used special greenhouses to enjoy them year-round. For a quirky treat, try pan-frying thick slices with dill and butter for a savory side dish! #Cucumber #Gardening #Cooking

#Fresh and healthy cucumbers🥒 #Cucumber farming at its best #Green, crisp, and full of nutrients. #Well done A refreshing crop to grow #Great work Cucumbers thrive under good care.

Wow! I had no idea cats were afraid of cucumbers. That's very odd to me. 🤣🤣🤣🤣
New gene expression analysis by Zhang et al. (2025) identifies key regulatory genes in 10 gene families that control woodiness and defense in cucumber. Crucial targets for stress-tolerant crop development! Read the study bit.ly/4nLYnE7 #cucumber #lignin #plantsci

Yet more yummy cucumbers on the way 💛🥒🌼💛 I really must post our cucumber cake recipe! Blue sky this morning after rain all day yesterday 💦☀️ I hope you can enjoy your Sunday 🌿 #SundayYellow #yellowflowers #cucumber #gyo

"His life stuck with cucumber 😂" #cucumber #kid #RevengedLove #bb27 #SecretStory #ساعه_استجابه #يوم_الجمعة
The Cucumber Question Josh may have bitten off more than he can chew with this one! #bobandtom #cucumber #comedy

Cucumber Raita Vs Boondi Raita: Which Is Lighter On The Stomach? food.ndtv.com/health/cucumbe… #cucumber #boondi #raita
#Wheat cover #crop accelerates the decomposition of #cucumber #root litter by altering the #soil #microbial community 🖇️doi.org/10.1016/j.jia.… #agroecology

New gene expression analysis by Zhang et al. (2025) identifies key regulatory genes in 10 gene families that control woodiness and defense in cucumber. Crucial targets for stress-tolerant crop development! Read the study bit.ly/4nLYnE7 #cucumber #lignin #plantsci

#VegetableRes CsWOX1 directly regulates CsRVE6 & CsPin1At genes, linking circadian rhythm & auxin transport to leaf shape in cucumber. Key for morphogenesis. @MaximumAcademic @PlantPhys #Cucumber #LeafDevelopment Details: maxapress.com/article/doi/10…

ONIX (WS-7820) bit.ly/4piGjCz is a parthenocarpic slicer #cucumber ideal for export. Vigorous plants suit long or short cycles. Contact us via:📞 (760) 353-7333, or 📧 [email protected]
Some treats for the 🦃 Day table landing in the shop from @alesongbrewing 🍻 Cucumber Enlightenmint #cucumber #mint #sour #frenchoak Rhino Suit #imperial #milkstout #bourbonbarrel Petite 🍒 Parliament #barrelaged #sourred Senor Rhino #mexicanchocolate

#TIH Plastic mulching + FYM & NPK fertilizer boosts cucumber yield (27.97 t/ha) & profit in Nepal. A winning combo for sustainable farming. @MaximumAcademic @NewPhyt #Cucumber #SustainableAgriculture Detais: maxapress.com/article/doi/10…

instead of chaos, both platforms ( $POOL) shows you the trades nobody talks about. ( $CUCUMBER) helps you ride them with clarity, incase you don't know, I rest my case, Gn. #CUCUMBER #SilentSignals #SmartTrading #ArbusChirps #CryptoAI
#Chickens love #cucumber, hate the peel. youtu.be/Vcw-ND7O5QY

youtube.com
YouTube
Chickens love cucumber, hate the peel.
Currently working on a custom Cucumber Event Plugin to capture internal execution data Interesting part? The event lifecycle gives you way more control than I expected. You can hook into test start, step start, step finish, scenario finish, everything #Cucumber #TestAutomation
In this blog, you will learn how to pass arguments to step definitions when using Cucumber and Spring Boot. Cucumber is a tool that supports BDD. #java #cucumber mydeveloperplanet.com/2024/06/12/cuc…
#Fresh and healthy cucumbers🥒 #Cucumber farming at its best #Green, crisp, and full of nutrients. #Well done A refreshing crop to grow #Great work Cucumbers thrive under good care.

Crisp cucumbers! Top tip: grow them on a trellis to save space and get straighter fruit. Ancient Romans used special greenhouses to enjoy them year-round. For a quirky treat, try pan-frying thick slices with dill and butter for a savory side dish! #Cucumber #Gardening #Cooking

Have you tried this amazing variety of cucumber 🥒? English cucumbers, also known as hothouse or burpless cucumbers, are a popular variety characterized by their long, slender shape, smooth, thin skin, and mild, slightly sweet flavor! #Cucumber #EnglishCucumber




#Cucumber is a nutritious fruit with a high water content. Eating cucumber may help lower blood sugar, prevent constipation, support weight loss, and more. To maximize cucumber’s health benefits, eat the peel, too. #health #HealthyEating #HealthyFoods

#Wheat cover #crop accelerates the decomposition of #cucumber #root litter by altering the #soil #microbial community 🖇️doi.org/10.1016/j.jia.… #agroecology
The tomatoes have settled into a steady flow at the moment 🍅🌿 The under gardener is happily pickling his mini cucumbers 🥒 #tomatoes #Cucumber #homegrown #kitchengarden

Hydrate your skin from within! 🥒💧 Drinking cucumber juice 3–4 times a week can boost hydration, support collagen, flush out toxins, and keep your skin naturally glowing. Simple, effective, and refreshing! #DermatologistTip #GlowingSkin #cucumber #skinglow #lucknow #hydratedskin

Something went wrong.
Something went wrong.
United States Trends
- 1. #StrangerThings5 220K posts
- 2. Thanksgiving 660K posts
- 3. BYERS 48K posts
- 4. robin 85.3K posts
- 5. Reed Sheppard 5,265 posts
- 6. Afghan 274K posts
- 7. Podz 4,050 posts
- 8. holly 60.9K posts
- 9. Dustin 89.4K posts
- 10. National Guard 648K posts
- 11. Gonzaga 8,403 posts
- 12. Vecna 53.4K posts
- 13. hopper 15K posts
- 14. Jonathan 73.3K posts
- 15. Erica 16.1K posts
- 16. Amen Thompson 1,684 posts
- 17. #AEWDynamite 21.7K posts
- 18. noah schnapp 8,667 posts
- 19. derek 17.9K posts
- 20. Tini 9,063 posts








































































































